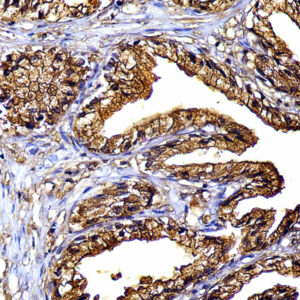
Anti- PSAP, Clone PASE/4LJ
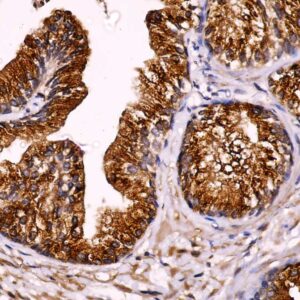
Anti-Prostein
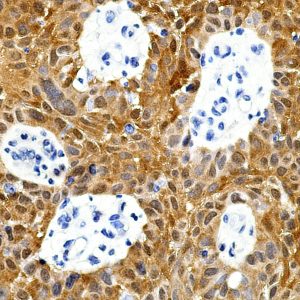
AMA08

P
Showing 41–60 of 78 resultsSorted by latest
-

Anti-p57/Kip2
Price range: $269.00 through $1,005.00 Select options This product has multiple variants. The options may be chosen on the product page -
![Anti-PAX-7 [EE-8]](https://biogenex.seosmo.click/wp-content/uploads/2022/08/PAX7_AMB93_1-300x300.jpg)
Anti-PAX-7 [EE-8]
Price range: $269.00 through $1,125.00 Select options This product has multiple variants. The options may be chosen on the product page -

Anti-Podoplanin[PDPN/1433]
Price range: $269.00 through $1,329.00 Select options This product has multiple variants. The options may be chosen on the product page -
Anti- PSAP, Clone PASE/4LJ
Price range: $269.00 through $1,160.00 Select options This product has multiple variants. The options may be chosen on the product page -
Anti-Prostein, Clone A-5
Price range: $269.00 through $1,275.00 Select options This product has multiple variants. The options may be chosen on the product page -

Anti-PTEN, Clone 6H2.1
Price range: $269.00 through $1,305.00 Select options This product has multiple variants. The options may be chosen on the product page -

Anti-PAX5, Clone PAX5/3735
Price range: $489.00 through $1,249.00 Select options This product has multiple variants. The options may be chosen on the product page -

Anti-PGP9.5/UchL1
Price range: $269.00 through $1,329.00 Select options This product has multiple variants. The options may be chosen on the product page -

Anti-Perforin, Clone PRF1/2470
Price range: $269.00 through $1,359.00 Select options This product has multiple variants. The options may be chosen on the product page -
Anti-p16
Price range: $269.00 through $1,485.00 Select options This product has multiple variants. The options may be chosen on the product page -

Anti-p16, Clone 16p04
Price range: $269.00 through $1,212.00 Select options This product has multiple variants. The options may be chosen on the product page -

Anti-Prolactin
Price range: $269.00 through $935.00 Select options This product has multiple variants. The options may be chosen on the product page -

Anti-PAX-5
Price range: $489.00 through $1,265.00 Select options This product has multiple variants. The options may be chosen on the product page -

Anti-P-Tyr
Read more -

Anti-P-Tyr
Price range: $269.00 through $1,840.00 Select options This product has multiple variants. The options may be chosen on the product page -

Anti-PD-1
Price range: $509.00 through $1,305.00 Select options This product has multiple variants. The options may be chosen on the product page -

Anti-p16 (INK4a)
Price range: $250.00 through $1,513.00 Select options This product has multiple variants. The options may be chosen on the product page -

Anti-Pax-5
Price range: $250.00 through $935.00 Select options This product has multiple variants. The options may be chosen on the product page -

Anti-PIN4
Read more -

Anti-P63
Price range: $260.00 through $1,499.00 Select options This product has multiple variants. The options may be chosen on the product page

